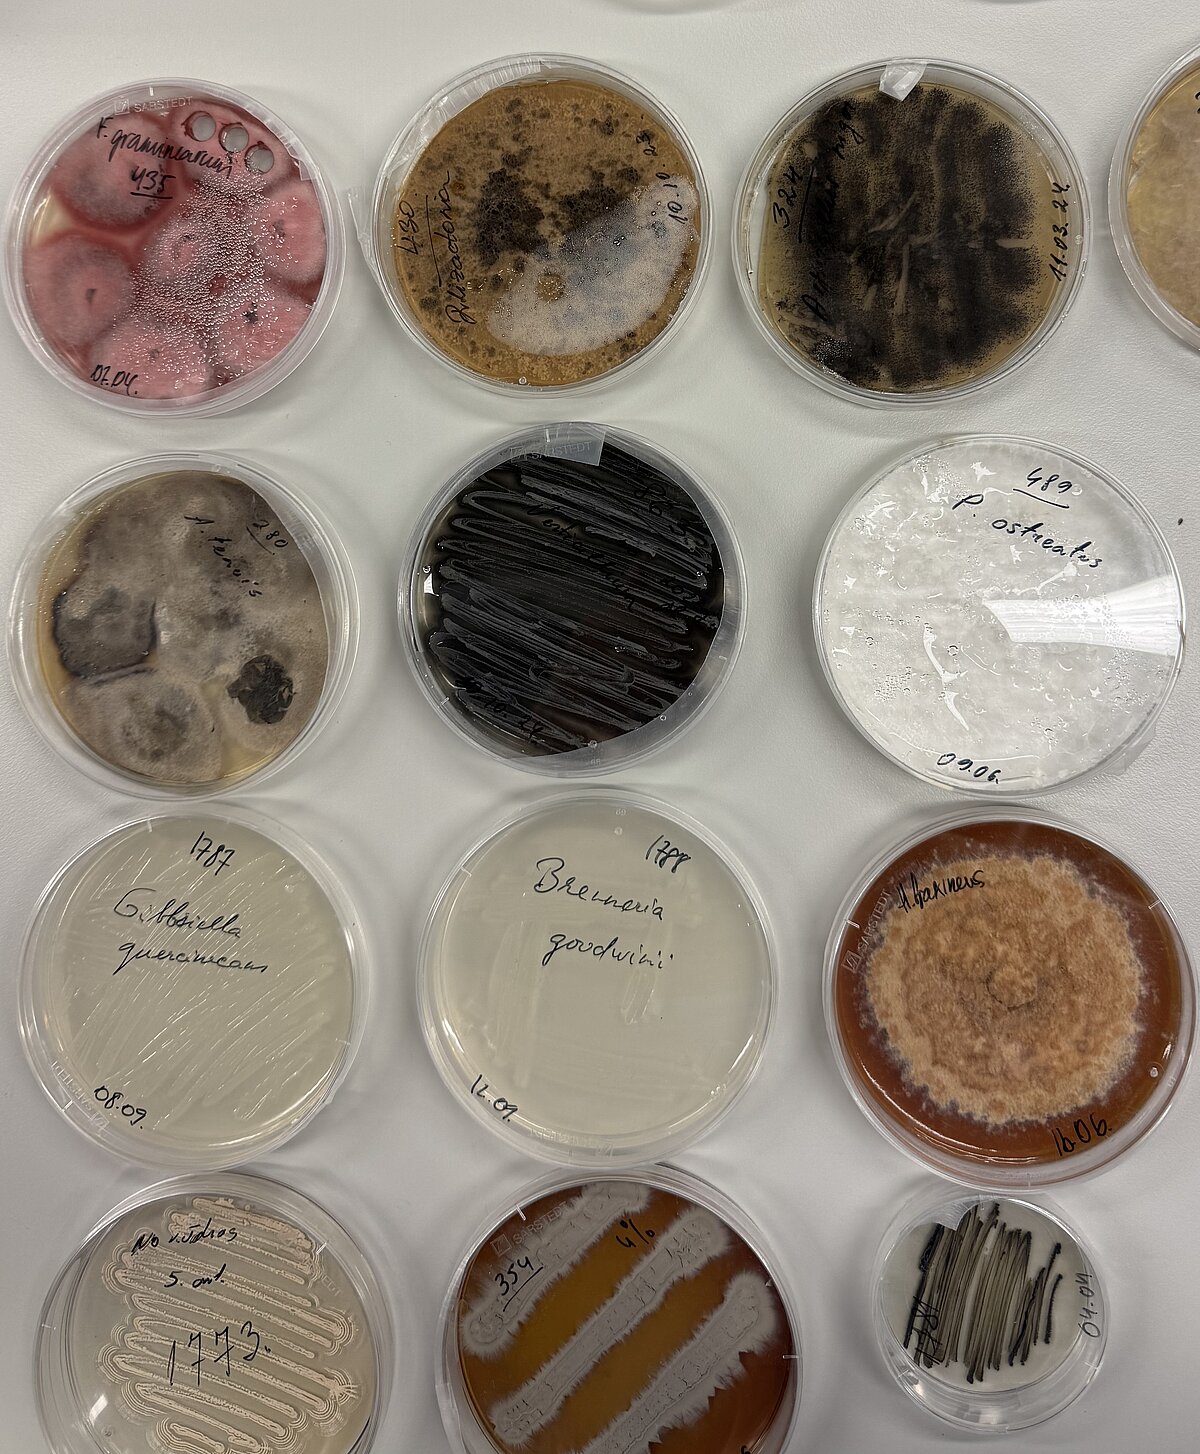

During the event, visitors had the opportunity to learn about the principles, goals, and services offered by MIRRI-ERIC to the scientific community. The presentation explained how this European research infrastructure promotes the preservation, accessibility, and utilization of microbial resources, while also supporting research excellence and international collaboration in the fields of biotechnology and biomedicine.
The aim of the informational session was to raise awareness of Latvia’s involvement in MIRRI-ERIC and to highlight the benefits this collaboration provides to Latvian scientists and research institutes. Attendees could ask questions, learn about project activities, and receive informational materials.
The activities of the Latvian National Node of the Microbial Resource Research Infrastructure, as well as the organization of the event, are supported by the ERDF co-funded project No. 1.1.1.5/3/25/I/011 “University of Latvia and Institutes in the European Research Area—Excellence in Research and Collaboration.”


 CONFERENCE
CONFERENCE